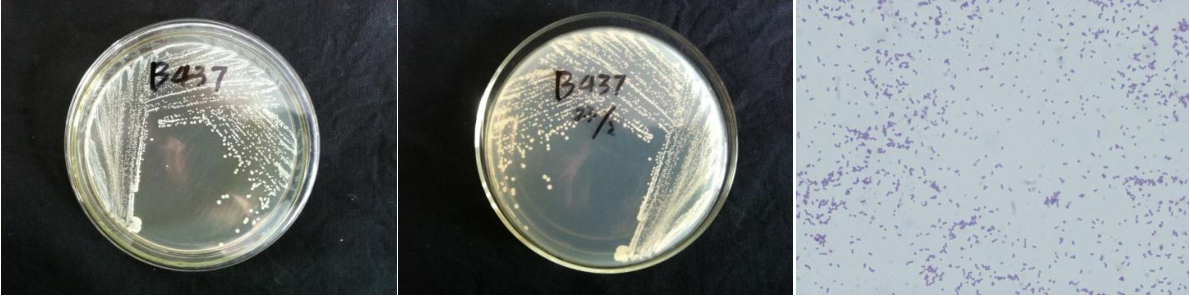

Loading...
| StrainNO | B437 |
| Classification | Staphylococcus |
| 16s rDNA sequence | GGTGTGTACAAGACCCGGGAACGTATTCACCGTAGCATGCTGATCTACGATTACTAGCGATTCCAGCTTCATGTAGTCGAGTTGC AGACTACAATCCGAACTGAGAACAACTTTATGGGATTTGCATGACCTCGCGGTTTAGCTGCCCTTTGTATTGTCCATTGTAGCAC GTGTGTAGCCCAAATCATAAGGGGCATGATGATTTGACGTCATCCCCACCTTCCTCCGGTTTGTCACCGGCAGTCAACTTAGAGT GCCCAACTAAATGCTGGCAACTAAGTTTAAGGGTTGCGCTCGTTGCGGGACTTAACCCAACATCTCACGACACGAGCTGACGACA ACCATGCACCACCTGTCACTTTGTCCCCCGAAGGGGAAGGCTCTATCTCTAGAGTTGTCAAAGGATGTCAAGATTTGGTAAGGTT CTTCGCGTTGCTTCGAATTAAACCACATGCTCCACCGCTTGTGCGGGTCCCCGTCAATTCCTTTGAGTTTCAACCTTGCGGTCGT ACTCCCCAGGCGGAGTGCTTAATGCGTTAGCTGCAGCACTAAGGGGCGGAAACCCCCTAACACTTAGCACTCATCGTTTACGGCG TGGACTACCAGGGTATCTAATCCTGTTTGATCCCCACGCTTTCGCACATCAGCGTCAGTTACAGACCAGAAAGTCGCCTTCGCCA CTGGTGTTCCTCCATATCTCTGCGCATTTCACCGCTACACATGGAATTCCACTTTCCTCTTCTGCACTCAAGTTTCCCAGTTTCC AATGACCCTCCACGGTTGAGCCGTGGGCTTTCACATCAGACTTAAGAAACCGCCTACGCGCGCTTTACGCCCAATAATTCCGGAT AACGCTTGCCACCTACGTATTACCGCGGCTGCTGGCACGTAGTTAGCCGTGGCTTTCTGATTAGGTACCGTCAAGACGTGCATAG TTACTTACACATTTGTTCTTCCCTAATAACAGAGTTTTACGATCCGAAGACCTTCATCACTCACGCGGCGTTGCTCCGTCAGGCT TTCGCCCATTGCGGAAGATTCCCTACTGCTGCCTCCCGTAGGAGTCTGGACCGTGTCTCAGTTCCAGTGTGGCCGATCACCCTCT CAGGTCGGCTACGTATCGTTGCCTTGGTAAGCCGTTACCTTACCAACTAGCTTCCATCTATAAGTGATAGCAAAACCATCTTTCA CTTTAGAACCATGCGGTTCTAAATGTTATCCGGCATTAGCCCCGGTTTCCCGGAGTTATTCCAGTCTTATAGGTAGGTTACCCACGT |
| Strain Morphology Photos | |
| Morphological Description | round;clam white;steamed bun shaped;edge neatly;slippy;sticky;spherical;no spore |